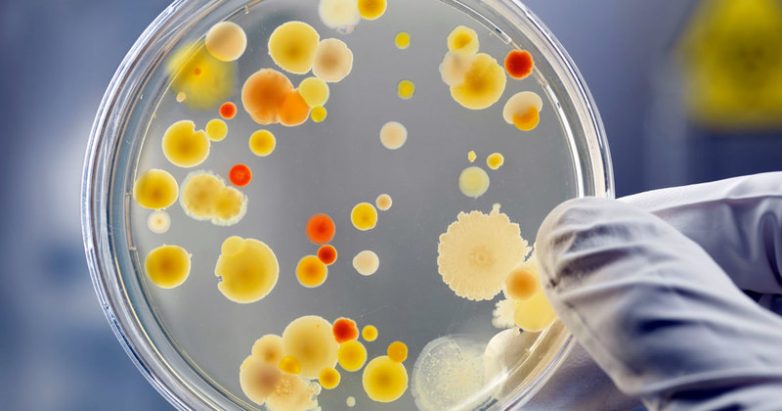

Чего боится стафилококк и другие бактерии? Как обеззаразить дом
Воздушные массы переносят смог на огромные расстояния, и отравленный воздух вдыхают люди на всей планете. Проведенные исследования в 130 странах мира подтвердили, что самой частой экологической причиной болезней и преждевременной смерти, является отравленный воздух. В статье рассмотрим, как обеззаразить воздух в своем доме безопасным и эффективным способом.

Среди всех наиболее изученных типов загрязнения воздушных масс, наибольшую тревогу вызывают тонкодисперсные частицы. Они имеют диаметр меньше 2,5 мкм, что позволяет им с легкостью проникать через органы дыхания и легочную ткань в кровоток и вызывать хронические процессы, аллергические и воспалительные болезни.
Американское издательство респираторной и реаниматологической медицины опубликовало данные исследования, которые подтвердили, что самые популярные для уборки средства бытовой химии, могут резко усилить отрицательное воздействие мелкодисперсных частиц. Применение в течение 20 лет обычного бытового моющего средства точно так же ухудшает легочную деятельность, как и выкуривание пачки сигарет в течение того же срока. До блеска убранный дом вызывает самые положительные эмоции, но достижение чистоты и порядка не должно происходить за счет здоровья всей семьи.
Но токсические вещества не всегда вызывают порчу продуктов. Бактерии Staphylococcus (золотистого стафилококка) могут быть на любых продуктах. Кроме этого, у четверти населения земного шара эти возбудители находятся на волосах, кожных покровах, руках, и могут быть с легкостью перенесены на другого человека.
Сами бактерии могут быть уничтожены под воздействием высоких температур при приготовлении еды, но вырабатываемые ими токсины в продуктах, не всегда можно устранить. По мере накопления они синтезируют очень крепкую биологическую оболочку, которая способна устоять перед различными попытками ее удаления.

Действие эфиров орегано было более эффективным для удаления патогенов с предметов из нержавеющей стали, чем обычно применяемая натриевая соль. Но в отличие от соли, эфирное масло не вызывает появления ржавчины. Кроме этого, доказана высокая эффективность эфиров орегано по уничтожению кишечных бактерий и сальмонеллы.

Американские исследования наиболее распространенных патогенов скота, установили способность масла орегано защищать от воспалительных повреждений, и приводить патогенную микрофлору к гибели. Корма, содержащие орегано, проявили значительную активность по уничтожению грамотрицательных и грамположительных возбудителей.
Различные исследования установили эффективность масла орегано против:
E.coli, Salmonella Typhimurium, синегнойной палочки;
золотистого стафилококка, сенной палочки;
гельминтов и раковых клеток;
дрожжей, спор сибирской язвы;
возбудителей различных инфекций.
Оно обладает значительным антиоксидантным, противовирусным, обеззараживающим, противогрибковым и другими уникальными свойствами.
Масло орегано помогает:
предотвратить скопления слизи и мокроты в верхних и нижних дыхательных путях;
облегчать проявления респираторных инфекций;
уменьшать артритные и травматические боли;
лечить грибковые инфекции;
обеспечить защиту от простудных и вирусных заболеваний;
умешать гиперчувствительность к аллергическим раздражителям.
Чтобы приготовить универсальный очиститель, влейте в стакан воды две чайные ложки кастильского мыла и добавить 20 капель эфирного масла. Все ингредиенты смешайте в пульверизаторе, хорошо встряхните и применяйте для очищения всех поверхностей.
Если нужно приготовить большое количество раствора, то в ¼ чашки белого уксуса, добавьте 10 капель лимонного масла и 4 капли душицы. Влейте эту смесь в ведро воды и используйте для обеззараживания любых помещений.

Налейте воду в кастрюлю и доведите ее до закипания, потом отставьте. В банку положите листья и залейте их маслом в соотношении 1:1. Банку нужно закрыть крышкой и поставить в кипяток на 10 мин, чтобы эфиры высвободились в масло, а затем поместить на солнечную сторону окна, на неделю или две, периодически встряхивая. По истечения этого времени, масло из банки следует перелить в стерильную тару и хранить ее в холодильнике. Можно добавить консервант – несколько капель масла семечек грейпфрута.
Втирание в кожу домашнего масла эффективно помогает от болей в голове, носовых пазухах и мышцах. Оно успокаивает раздраженную и воспаленную кожу при укусах насекомых, ожогах, артритах и других заболеваниях.

Среди всех наиболее изученных типов загрязнения воздушных масс, наибольшую тревогу вызывают тонкодисперсные частицы. Они имеют диаметр меньше 2,5 мкм, что позволяет им с легкостью проникать через органы дыхания и легочную ткань в кровоток и вызывать хронические процессы, аллергические и воспалительные болезни.
Американское издательство респираторной и реаниматологической медицины опубликовало данные исследования, которые подтвердили, что самые популярные для уборки средства бытовой химии, могут резко усилить отрицательное воздействие мелкодисперсных частиц. Применение в течение 20 лет обычного бытового моющего средства точно так же ухудшает легочную деятельность, как и выкуривание пачки сигарет в течение того же срока. До блеска убранный дом вызывает самые положительные эмоции, но достижение чистоты и порядка не должно происходить за счет здоровья всей семьи.
Возбудители пищевых отравлений
Нас окружает огромное количество болезнетворных бактерий и вирусов, способных вызывать отравления пищевыми продуктами, тяжелые заболевания и даже смерть. Самые распространенные из них — бактерии золотистого стафилококка, кишечной палочки, сальмонеллы, норовируса и другие. Они в изобилии имеются на продуктах питания и, размножаясь в теплом помещении, отравляют и портят их.Но токсические вещества не всегда вызывают порчу продуктов. Бактерии Staphylococcus (золотистого стафилококка) могут быть на любых продуктах. Кроме этого, у четверти населения земного шара эти возбудители находятся на волосах, кожных покровах, руках, и могут быть с легкостью перенесены на другого человека.
Сами бактерии могут быть уничтожены под воздействием высоких температур при приготовлении еды, но вырабатываемые ими токсины в продуктах, не всегда можно устранить. По мере накопления они синтезируют очень крепкую биологическую оболочку, которая способна устоять перед различными попытками ее удаления.
Применение эфирных масел против вредных микроорганизмов
Золотистый стафилококк вызывает подавляющее большинство пищевых отравлений во всем мире. Был проведен ряд исследований свойств различных эфирных масел, и воздействие их на патогенную микрофлору. В результате работ были приведены убедительные доказательства высокой эффективности масел душицы (другое название — орегано) для устранения био оболочек Staphylococcus. Кроме этого, это эфирное масло намного уменьшают количество вредоносных структур, прикрепленных к поверхности продуктов.Действие эфиров орегано было более эффективным для удаления патогенов с предметов из нержавеющей стали, чем обычно применяемая натриевая соль. Но в отличие от соли, эфирное масло не вызывает появления ржавчины. Кроме этого, доказана высокая эффективность эфиров орегано по уничтожению кишечных бактерий и сальмонеллы.

Американские исследования наиболее распространенных патогенов скота, установили способность масла орегано защищать от воспалительных повреждений, и приводить патогенную микрофлору к гибели. Корма, содержащие орегано, проявили значительную активность по уничтожению грамотрицательных и грамположительных возбудителей.
Различные исследования установили эффективность масла орегано против:
E.coli, Salmonella Typhimurium, синегнойной палочки;
золотистого стафилококка, сенной палочки;
гельминтов и раковых клеток;
дрожжей, спор сибирской язвы;
возбудителей различных инфекций.
Оно обладает значительным антиоксидантным, противовирусным, обеззараживающим, противогрибковым и другими уникальными свойствами.
Масло орегано помогает:
предотвратить скопления слизи и мокроты в верхних и нижних дыхательных путях;
облегчать проявления респираторных инфекций;
уменьшать артритные и травматические боли;
лечить грибковые инфекции;
обеспечить защиту от простудных и вирусных заболеваний;
умешать гиперчувствительность к аллергическим раздражителям.
Как приготовить моющее средство самостоятельно
Чтобы уничтожить большинство патогенных микроорганизмов, достаточно добавить эфирное масло орегано в любое средство для уборки. Не рекомендуется использовать приготовленный раствор в многоразовых пластиковых бутылках, чтобы предотвратить отщелачивание химических веществ из пластика. Лучше применять для этого стеклянные емкости.Чтобы приготовить универсальный очиститель, влейте в стакан воды две чайные ложки кастильского мыла и добавить 20 капель эфирного масла. Все ингредиенты смешайте в пульверизаторе, хорошо встряхните и применяйте для очищения всех поверхностей.
Если нужно приготовить большое количество раствора, то в ¼ чашки белого уксуса, добавьте 10 капель лимонного масла и 4 капли душицы. Влейте эту смесь в ведро воды и используйте для обеззараживания любых помещений.

Как приготовить масло самостоятельно
Для приготовления масла понадобятся зеленые листочки орегано, растительное масло из виноградных косточек, миндаля или оливок и стерильная баночка с тугой крышкой.Налейте воду в кастрюлю и доведите ее до закипания, потом отставьте. В банку положите листья и залейте их маслом в соотношении 1:1. Банку нужно закрыть крышкой и поставить в кипяток на 10 мин, чтобы эфиры высвободились в масло, а затем поместить на солнечную сторону окна, на неделю или две, периодически встряхивая. По истечения этого времени, масло из банки следует перелить в стерильную тару и хранить ее в холодильнике. Можно добавить консервант – несколько капель масла семечек грейпфрута.
Втирание в кожу домашнего масла эффективно помогает от болей в голове, носовых пазухах и мышцах. Оно успокаивает раздраженную и воспаленную кожу при укусах насекомых, ожогах, артритах и других заболеваниях.
Только зарегистрированные и авторизованные пользователи могут оставлять комментарии.

